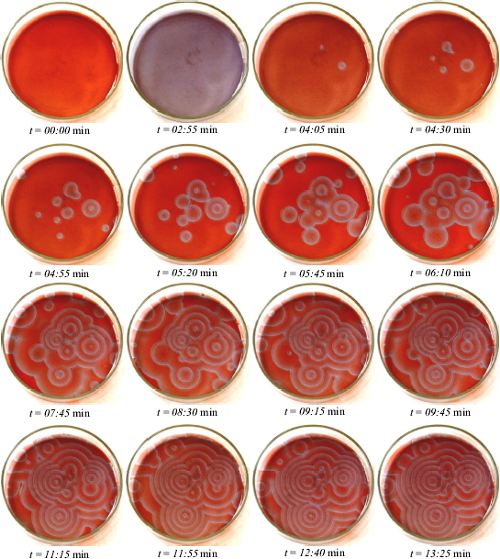
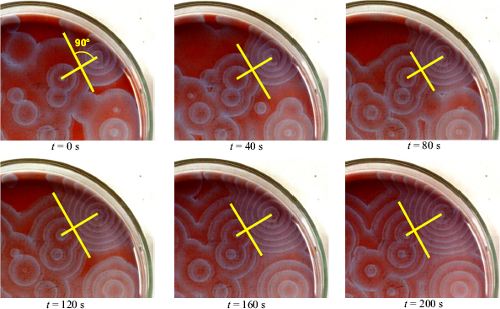

2.4 Versuche: räumliche Oszillation
2.4.1 Versuchsaufbau
Um die Wellenmuster, die sich in einer dünnen Schicht der BZR bilden, beobachten zu können, habe ich das folgende Experiment durchgeführt. Ein abgewandelter Ansatz wird etwa 0,5 - 2 mm hoch in eine saubere Petrischale gegossen. Man achtet dabei darauf, dass sich die Lösung gleichmäßig über den Boden der Schale verteilt. Danach lässt man das Ganze einfach stehen und wartet.Um die zu erwartenden Wellenmuster zu fotografieren kann man die Schale entweder auf einen Tageslichtprojektor stellen und direkt oder indirekt (Projektion) aufnehmen, oder man stellt sie auf ein Blatt weißes Papier und fotografiert von oben.
Als Rezept habe ich wieder den Ansatz von RICHARD J.
FIELD benutzt, der in Tabelle
3 angegeben ist.
| Reaktand | Konzentration der | eingesetzte |
|---|---|---|
| Vorratslösung [mol/l] | Menge [ml] | |
| KBrO3 | 0,5 | 15,0 |
| HMal | 1,5 | 3,0 |
| H2SO4 | 5 | 2,0 |
| KBr | 0,3 | 5,0 |
| Ferroin | 0,01 | 5,0 |
2.4.2 Ergebnisse
Die folgenden zwei Abbildungen 11 und 12 zeigen die Ergebnisse meiner Versuche in einer Schale mit dem Durchmesser 10 cm. Außerdem lege ich dieser Facharbeit einige Abzügen von meinen Photos bei.
Abb. 11: Musterbildung in der BZR (eigener Versuch). Das Zeitintervall
zwischen den Aufnahmen ist unter den Bildern angegeben. Durchmesser der
Schale: 10 cm. Aufnahmen der Schale auf einem weißen Blatt Papier.
Die Bilder wurden digital nachbearbeitet.

Abb. 12: Musterbildung in der BZR (eigener Versuch). Zeitintervall
zwischen den Aufnahmen: 5 s. Die Farben sind durch die Rotempfindlichkeit
des Filmes verfälscht. Aufnahme einer Projektion der Schale mithilfe
eines Tageslichtprojektors.
Die Abbildungen 11 und 12 zeigen konzentrische Wellenmuster, wie sie aus der BZR entstehen. Die Farben der Aufnahmen in Abbildung 12 sind etwas verfälscht, weil das Licht des Tageslichtprojektors einen hohen Rot-Anteil besitzt, und der Film - ein ASA-100/200-Standardfilm - eine besonders hohe Empfindlichkeit im roten Spektralbereich aufweist. Im zweiten Bild ist eine etwas vergrößerte Gruppe von einigen Wellenzentren zu sehen. Die Ausbreitungsgeschwindigkeit beträgt hier etwa 14 mm/min (gemessen in der rechten Spalte von Abbildung 12). Die Wellengrenzen sind in beiden Aufnahmenserien ausgefranst, weil sich die Vibrationen des Ventilators des Overhead-Projektors auf die Lösung übertragen.
Man kann die Reaktion an einer bestimmten Stelle initiieren, wenn man eine heiße Nadel, oder einen heißen Draht kurz in die Lösung taucht. Die Gasbläschen, die entstehen, erkennt man auf diesen Aufnahmen als dunkle runde Flecken, da sie das Licht des Projektors streuen.
Abb. 13: Musterbildung in der BZR (eigener Versuch). Zeitintervall
zwischen den Aufnahmen: 40 s. Direkte Aufnahmen der Schale auf einem weißen
Papier. Die Bilder wurden digital nachbearbeitet. Die dicken gelben Linien
markieren die Verbindungslinie zwischen zwei benachbarten Störungszentren.
Die dünnen gelben Linien markieren die Stellen an der sich die Wellenfronten
dieser Zentren gerade berühren.
2.4.3 Deutung
Im Prinzip läuft bei räumlicher Reaktionsführung die gleiche Reaktion ab, wie bei einem gerührten System. Der einzige Unterschied besteht darin, dass sich die Reaktion nicht nur über die Zeit, sondern auch über den Raum ausbreitet. Am Anfang ist die gesamte Schicht im reduzierten Zustand der BZR. Danach bilden sich an einige Stellen Zentren mit veränderten Konzentrationen, von denen die sichtbaren chemischen Wellen konzentrisch, oder spiralförmig ausgehen. Dies beruht darauf, dass die Reaktion von einer Raumeinheit auf eine benachbarte übergreift, indem die Substanzen zwischen den Raumeinheiten diffundieren. Ist zum Beispiel an einer Stelle gerade die Br--Konzentration sehr hoch, so greift diese hohe Konzentration auch auf die benachbarten Raumeinheiten über (Ausgleich des Konzentrationsgefälles) usw. So breitet sich ein gewisser Zustand der Reaktion über den Raum aus. Von innen heraus bildet sich dann aber die hohe Br--Konzentration (siehe Beispiel) durch das Ablaufen der BZR wieder zurück. Somit breitet sich ein mehr, oder minder breites Band mit einer hohen Br--Konzentration aus, das sich farblich vom Rest der Schicht absetzt. Passiert dies oft hintereinander, so beobachtet man mehrere konzentrische Wellenfronten, die vom Zentrum ausgehen [Walker 1980].Die Störzentren können, wie im letzten Abschnitt erwähnt wurde, durch eine heiße Nadel erzeugt werden. Man verändert dabei durch Verdampfen die Konzentrationen. Aber auch CO2-Bläschen, Kratzer im Glas oder Staubkörner können Störzentren sein.
Anhand von Abbildung 13 kann man einige Aussagen
über die Natur von chemischen Wellen machen. Sie unterscheiden sich
nämlich in einigen wichtigen Punkten von anderen Wellenerscheinungen,
wie dem Schall, oder dem Licht. Zum einen werden chemische Wellen von Hindernissen
nicht reflektiert. Dies sieht man daran, dass etwa die Wellen, die in den
Aufnahmen auf die Gefäßwand treffen, nicht wieder zurücklaufen,
sondern einfach verschwinden. Ein weiterer Unterschied besteht in der Interaktion
von verschiedenen Wellenfronten: Licht- oder Schallwellen können sich
durchdringen und interferieren, chemische Wellen löschen sich grundsätzlich
aus. Dies sieht man an den Stellen, die in Abbildung
13 mit einem gelben Strich markiert sind. Hier treffen jeweils zwei
Wellenfronten aufeinander und löschen sich aus. Dabei bildet sich
eine gedachte Linie, an der die Auslöschung stattfindet, die sich
immer in Richtung des Störzentrums mit der nierdrigeren Frequenz bewegt
[Walker 1980].

[ Home/Inhalt | Elektronik
| Download | Links
| jkrieger.de | Impressum | Datenschutzerklärung ]
© 2001 by Jan
W. Krieger --- last
updated: 04.08.2019
